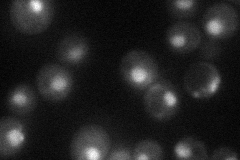
YDR359C
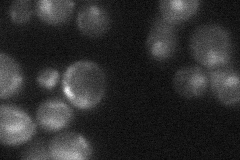
YDR359C
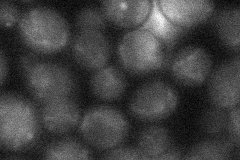
YDR359C
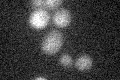
YDR359C

View description
Component of the NuA4 histone acetyltransferase complex; acts as a platform for assembly of NuA4 subunits into the native complex; required for initiation of pre-meiotic DNA replication, likely due to its requirement for expression of IME1
Localization:
Intensity:
Fold change:
Significance:
-
C’ GFP library in SD

below threshold17.57 -
N' NOP1pr-GFP in SD
nucleus34.7041 -
N' TEF2pr-mCherry in SD

nucleus14.4534 -
N' NATIVEpr-GFP in SD
nucleus24.0693 -
N' TEF2pr-VC and Cyto-VN in SD
below threshold25.824 -
C’ GFP library in SD+DTT

cytosol14.830.84No -
C’ GFP library in SD+H2O2

cytosol16.380.93No -
C’ GFP library in Starvation Media
cytosol15.630.88No -
C’ GFP library on the background of Pup2-DaMP

below threshold -
C’ GFP library on the background of CCT mutant

below threshold18.00481.0242No
